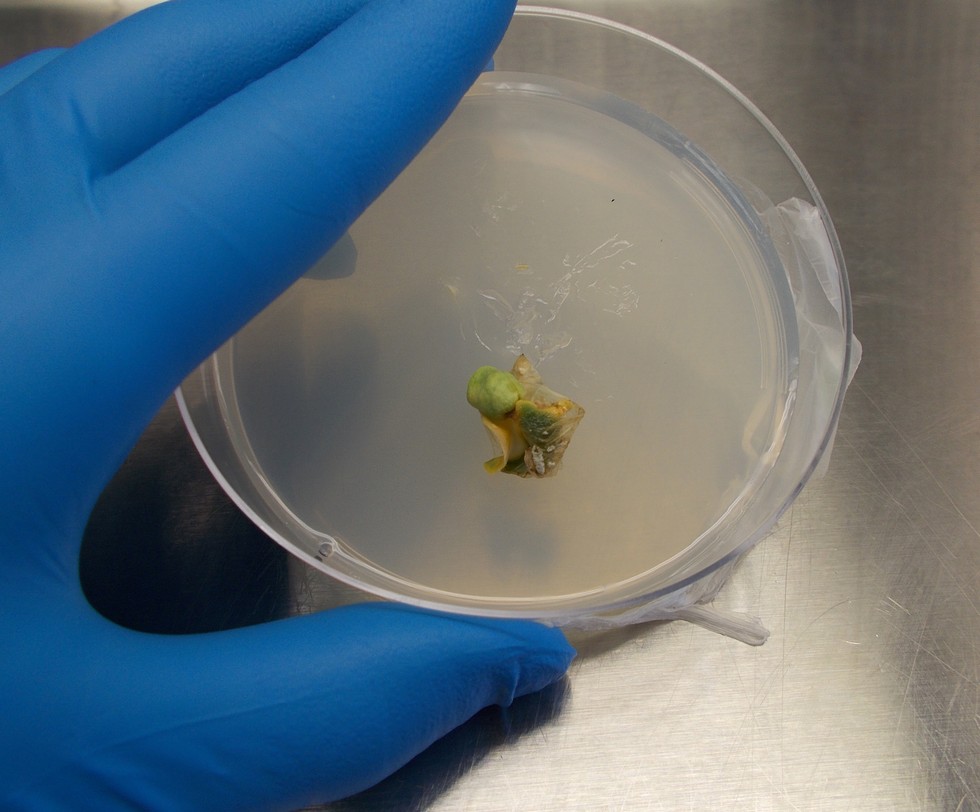

| |
|
Entry Date
|
Nick Name
|
Location
|
|
Wednesday, January 01, 2014
|

|
Matt D.
|
Connecticut
|
 |
Entry 31 of 189 |
 |
|
|
|
Picture taken Dec. �13 / Jan. �14
After much anticipation and getting the embryo to green-up there was never any radical produced:-(
Now there is the possibility of taking a small section of this plant material and getting to the develop callus, then taking the callus tissue and getting it to differentiate into roots and shoots to still get a plant. However, this would put me out of the spring time window. I am also fortunate to have two actively growing pumpkin plants right now in the greenhouse and while they may not be the 2328 Meier, they both come from very strong genetic backgrounds.
|
|
|